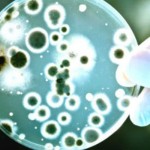
virus-gripa

Stavite ovu mješavinu pod jezik navečer prije spavanja i NIKADA SE NEĆETE BUDITI UMORNI!
Svakodnevno možete čuti nekoga kako govori: ‘tako sam umoran’… Nisu važni dob ili spol, mnogi ljudi se često žale na umor. Jedan dio tog problema može biti u tome da jednostavno ne ulažemo dovoljno vremena u spavanje.
Umor se često javlja zbog nedostatka sna, a šta prvo radimo da napunimo naše ‘baterije’? Pijemo kafu, odnosno unosimo kofein! Nažalost, on je samo kratkotrajna pomoć…
Ipak, na našu sreću postoji i mješavina koja nam na prirodan način daje energiju, a glavni sastojak je Himalajska sol!
Sve što je potrebno je da uzmete 5 kašikica organskog sirovog meda, i jednu čajnu kašiku himalajske soli, te sve pomješate u tegli.
Navečer, prije svakog spavanja ispod jezika stavite samo malu količinu i vidjćete nevjerovatne rezultate.
Izvor: ludodobola.com